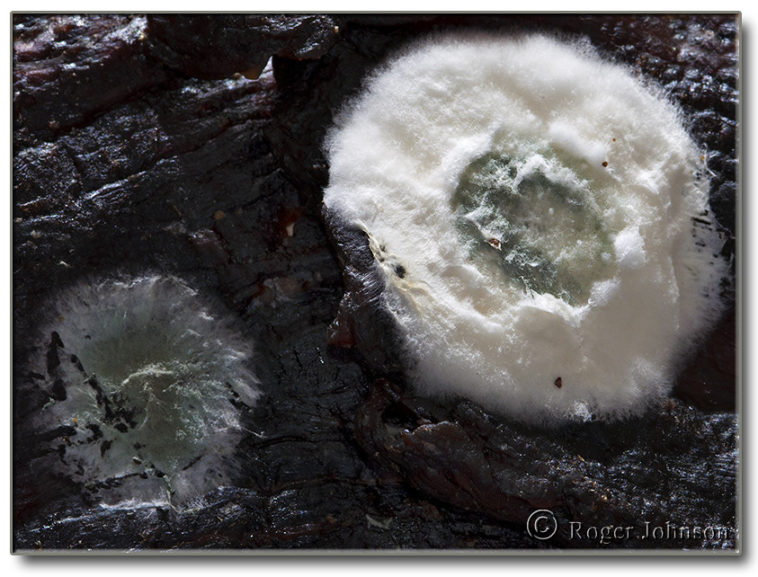
Why did my beef jerky mold?

Jerky will mold if not enough moisture has been removed from the meat during the drying process; therefore, it should have around 90% to 95% of the moisture in the meat removed during drying. If it doesn’t, the moisture still in the meat will cause mold spores to grow.
Consequently, How Long Will homemade beef jerky last?
If you follow the steps below, you can expect your homemade jerky to last 1-2 months after initial airtight packaging. When stored in ziplock type bags in a dark pantry, jerky will last about 1 week; In a refrigerator, jerky will last 1-2 weeks.
Also question is, Can moldy jerky be saved?
There are some kinds of mold which are safe to consume (blue cheese is a common example) but in general they are not. While you might often be fine eating a bit, there’s no guarantee, so to be safe you should throw out moldy food like your jerky.
Besides Why did my beef jerky turned white? White spots on beef jerky can be mold, fat, or salt. Proper identification is key. Fat and salt particles on the outside of beef jerky are perfectly safe to eat, but jerky that shows any signs of mold should be discarded.
Also, What’s the white stuff on beef jerky?
Meat has mineral salts in it, which are soluble in the oils/juices of the meat. As jerky dries, moisture in the meat evaporates into the air, and the salts can no longer stay dissolved. Instead, they get left behind and may form a visible deposit on the surface of the jerky. The deposit feels like a fine white powder.
Why does jerky not spoil?
Jerky is lean meat that’s been dried to extend its shelf life. … The drying process usually includes salting the meat to draw out moisture and preserve the product. And lack of water and a fairly high level of salt mean the meat doesn’t spoil that easily.
Contenus
20 Related Questions and Answers Found
Can you put raw meat in dehydrator?
The temperatures of dehydrators and oven dehydrating are not high enough to destroy harmful microorganisms that are typically present in raw meat. Even though fully dried jerky may appear done, it is not safe to eat unless it goes through an additional heat treatment. This can be done before or after the meat is dried.
Can you get botulism from jerky?
If these surviving bacteria are pathogenic, they can cause foodborne illness to those consuming the jerky. … The most serious additive is sodium nitrite, which is added to jerky to inhibit the growth of bacterial spores that cause botulism, a potentially deadly food borne illness.
Will mold on jerky hurt you?
The short answer is no, you’re probably not going to die from eating mold; you’ll digest it like any other food, and as long as you’ve got a relatively healthy immune system, the most you’ll experience is some nausea or vomiting due to the taste/idea of what you’ve just eaten.
Can you get sick from old beef jerky?
Old beef jerky or beef jerky that have gone bad contain a lot of bacteria like Salmonella, E. coli, etc. … So if you have devoured beef jerky that has gone bad, it can result in food poisoning that is characterized by nausea, vomiting, diarrhea, abdominal cramps, fever, weakness, headaches, and dehydration.
Will mold on beef jerky hurt you?
The short answer is no, you’re probably not going to die from eating mold; you’ll digest it like any other food, and as long as you’ve got a relatively healthy immune system, the most you’ll experience is some nausea or vomiting due to the taste/idea of what you’ve just eaten.
How can you tell if beef jerky has gone bad?
The telltale sign that beef jerky has gone rancid is the smell. It will often have a spoiled, off smell. If you encounter beef jerky that has either mold or shows signs of rancidity, discard and do not eat.
Do you need to refrigerate beef jerky?
It requires no refrigeration. Jerky can be made from almost any lean meat, including beef, pork, venison or smoked turkey breast. … To treat the meat, freeze a portion that is 6 inches or less thick at 0ºF or below for at least 30 days. Freezing will not eliminate bacteria from the meat.
Is smelly steak OK to eat?
A spoiled steak will have a potent odor that no longer smells like raw steak but instead has an ammonia-clad aroma. You’ll definitely know the odor when you smell it, and it’s a sure-fire sign that you should not plan to eat it!
Is white mold on meat dangerous?
Yes, some molds cause allergic reactions and respiratory problems. … And a few molds, in the right conditions, produce “mycotoxins,” poisonous substances that can make you sick. It won’t eat your insides.
Should you refrigerate jerky?
Storing the Jerky
Properly dried jerky will keep at room temperature two weeks in a sealed container. For best results, to increase shelf life and maintain best flavor and quality, refrigerate or freeze jerky.
How long should I dehydrate jerky?
Step 8 – Beef jerky takes around 4-5 hours to dry when dehydrating. Turn the dehydrator to 165° and let it run for about 4 hours until the internal temperature of the jerky reaches a safe 160° as per guidelines from the USDA.
Do you need curing salt for jerky?
I also recommend using curing salt when making turkey or chicken jerky due to salmonella. Better to be safe than sorry! … No jerky recipe NEEDS cure as long as beef is heated to 160°F and fowl to 165°F. But it is another line of defense to kill bacteria and allows your jerky to last longer.
Can you put too much cure in jerky?
Too much cure will make the jerky salty. … Letting it cure too long will make it too salty as well. If done correctly, you can cut the cure down by ½ tsp per pound of meat. The meat should still come out pink in the middle when it is finished cooking.
Does jerky cure kill bacteria?
Heating the jerky after dehydrating might not kill all bacteria due to it becoming more heat resistant during the drying process. … As an extra precaution; I ALWAYS pre-heat any turkey or chicken jerky I make, as well as use curing salt, to make sure it is safe to eat.
Can jerky make you sick?
The biggest safety concern when making jerky is the risk of allowing bacteria that can cause human illness to grow to high levels in the warm, dry environments of a food dehydrator or oven drying process. An added step of heating the meat either before or after drying is needed to destroy these bacteria.
Does smoking jerky kill bacteria?
If using a cooker or smoker to make jerky, be sure the product’s temperature reaches at least 160 F to ensure any bacteria are destroyed. … Do not smoke the jerky at lower temperatures and finish at a higher temperature because some bacteria can survive the drying process and not be killed during cooking.
Editors. 5 – Last Updated. 31 days ago – Authors. 6